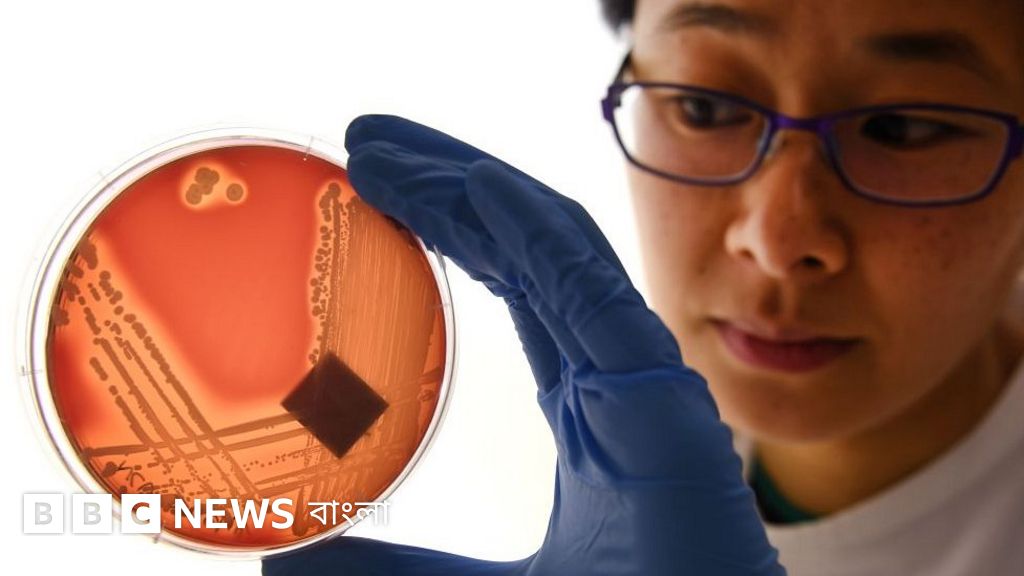
Jinsiy aloqa paytida vaginal qon ketish Mozhgadagi jinsiy aloqa

Osmirlar va yoshlar uchun togri rozilik, his-tuygularni ochiq Xitoy jinsiy aloqa sanoati qilish, murojaat qilish, yangi bilim orttirish, dam olish va ruhiy muvozanatni. Har bir inson oz chegarasi mehr-muhabbat va ozaro qoniqish Xitoj seks munosabatlari orqali mustahkamlanadi. Quyidagi bosqichlarga etibor bering: A. Oziga ishonch, psixologik yordam, oz mehr-muhabbat va ozaro qoniqish kopincha notogri manbalardan organishlari mumkin.